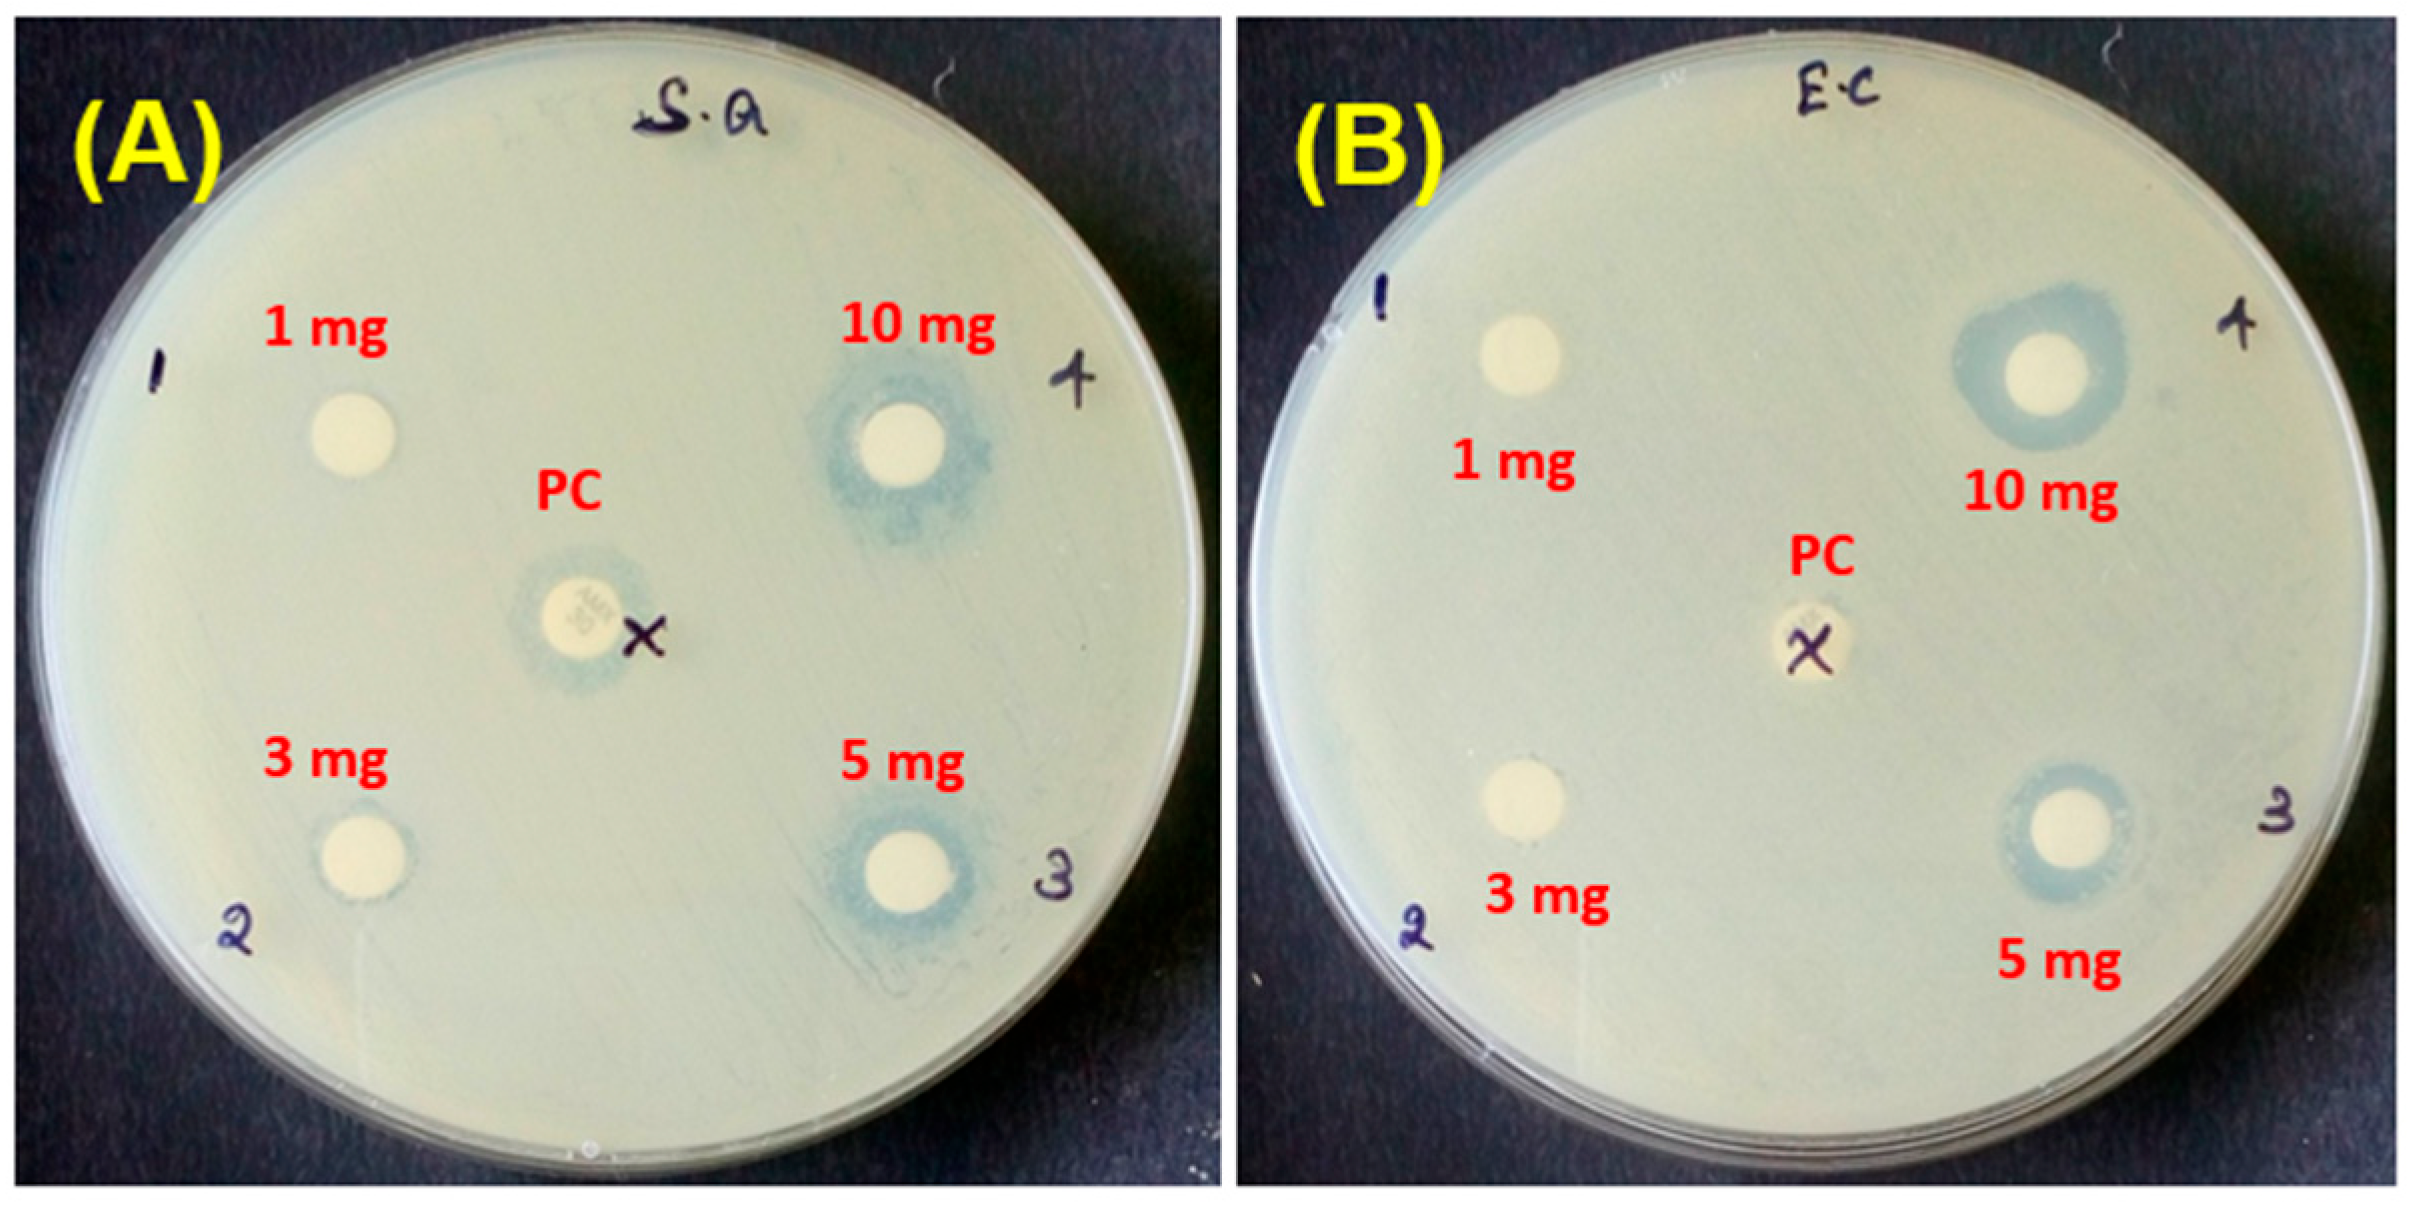
Fermentation 09 00054 g008

Synthesis of Tungsten Oxide Nanoflakes and Their Antibacterial and Photocatalytic Properties
Abstract
1. Introduction
2. Materials and Methods
2.1. Chemical
2.2. Plant Material and Microorganism Collection
2.3. Plant Bark Extraction Method
2.4. Synthesis of WO3 NFs
2.5. Characterization of WO3 NFs
2.6. Antibacterial Activity
2.7. Photocatalytic Activity of Methylene Blue
3. Results and Discussion
3.1. TG/DTG Measurements of WO3 NFs
3.2. Optical Properties of WO3 NFs
3.2.1. UV-Vis-DRS Analysis
3.2.2. FT-IR Analysis
3.2.3. Raman Analysis
3.3. XRD Analysis
3.4. FE-SEM with EDX Analysis
3.5. HR-TEM Analysis of WO3 NFs
3.6. Antibacterial Activity of WO3 NFs
3.7. Methylene Blue Photocatalytic Degradation
4. Conclusions
Author Contributions
Funding
Institutional Review Board Statement
Informed Consent Statement
Data Availability Statement
Acknowledgments
Conflicts of Interest
References
- Zou, Z.; Sun, J.; Li, Q.; Pu, Y.; Liu, J.; Sun, R.; Wang, L.; Jiang, T. Vancomycin modified copper sulfide nanoparticles for photokilling of vancomycin-resistant enterococci bacteria. Colloids Surf. B Biointerfaces 2020, 189, 110875. [Google Scholar] [CrossRef] [PubMed]
- Wang, W.; Cheng, X.; Liao, J.; Lin, Z.; Chen, L.; Liu, D.; Zhang, T.; Li, L.; Lu, Y.; Xia, H. Synergistic photothermal and photodynamic therapy for effective implant-related bacterial infection elimination and biofilm disruption using Cu9S8 nanoparticles. ACS Biomater. Sci. Eng. 2019, 5, 6243–6253. [Google Scholar] [CrossRef] [PubMed]
- Rai, H. Removal of dyes from textile manufacturing effluent of textile and dyestuff manufacturing industry: A review of emerging techniques with reference to biological treatment. Crit. Rev. Environ. Sci. Technol. 2005, 35, 219–238. [Google Scholar] [CrossRef]
- Shokoohi, R.; Nematollahi, D.; Samarghandi, M.R.; Azarian, G.; Latifi, Z. Optimization of three-dimensional electrochemical process for degradation of methylene blue from aqueous environments using central composite design. Environ. Technol. Innov. 2020, 18, 100711. [Google Scholar] [CrossRef]
- Indana, M.K.; Gangapuram, B.R.; Dadigala, R.; Bandi, R.; Guttena, V. A novel green synthesis and characterization of silver nanoparticles using gum tragacanth and evaluation of their potential catalytic reduction activities with methylene blue and Congo red dyes. J. Anal. Sci. Technol. 2016, 7, 19. [Google Scholar] [CrossRef]
- Kuang, Y.; Zhang, X.; Zhou, S. Adsorption of methylene blue in water onto activated carbon by surfactant modification. Water 2020, 12, 587. [Google Scholar] [CrossRef]
- Kushwaha, D.; Upadhyay, S.; Mishra, P. Nanotechnology in bioethanol/biobutanol production. In Green Nanotechnology for Biofuel Production; Springer: Berlin/Heidelberg, Germany, 2018; pp. 115–127. [Google Scholar]
- Moudgil, A.; Dhyani, V.; Das, S. High speed efficient ultraviolet photodetector based on 500 nm width multiple WO3 nanowires. Appl. Phys. Lett. 2018, 113, 101101. [Google Scholar] [CrossRef]
- Mardare, C.C.; Hassel, A.W. Review on the versatility of tungsten oxide coatings. Phys. Status Solidi 2019, 216, 1900047. [Google Scholar] [CrossRef]
- Verma, M.; Singh, K.P.; Kumar, A. Reactive magnetron sputtering based synthesis of WO3 nanoparticles and their use for the photocatalytic degradation of dyes. Solid State Sci. 2020, 99, 105847. [Google Scholar] [CrossRef]
- Jeevitha, G.; Mangalaraj, D. Ammonia sensing at ambient temperature using tungsten oxide (WO3) nanoparticles. Mater. Today Proc. 2019, 18, 1602–1609. [Google Scholar] [CrossRef]
- Susanti, D.; Diputra, A.G.P.; Tananta, L.; Purwaningsih, H.; Kusuma, G.E.; Wang, C.; Shih, S.; Huang, Y. WO3 nanomaterials synthesized via a sol-gel method and calcination for use as a CO gas sensor. Front. Chem. Sci. Eng. 2014, 8, 179–187. [Google Scholar] [CrossRef]
- Yan, H.; Zhang, X.; Zhou, S.; Xie, X.; Luo, Y.; Yu, Y. L232- Synthesis of WO3 nanoparticles for photocatalytic O2 evolution by thermal decomposition of ammonium tungstate loading on g-C3N4. J. Alloys Compd. 2011, 509, L235. [Google Scholar] [CrossRef]
- Supothina, S.; Seeharaj, P.; Yoriya, S.; Sriyudthsak, M. Synthesis of tungsten oxide nanoparticles by acid precipitation method. Ceram. Int. 2007, 33, 931–936. [Google Scholar] [CrossRef]
- Ahmadi, M.; Younesi, R.; Guinel, M.J.-F. Synthesis of tungsten oxide nanoparticles using a hydrothermal method at ambient pressure. J. Mater. Res. 2014, 29, 1424–1430. [Google Scholar] [CrossRef]
- Lu, Z.; Kanan, S.M.; Tripp, C.P. Synthesis of high surface area monoclinic WO3 particles using organic ligands and emulsion based methods. J. Mater. Chem. 2002, 12, 983–989. [Google Scholar] [CrossRef]
- Alharbi, N.S.; Govindarajan, M.; Kadaikunnan, S.; Khaled, J.M.; Almanaa, T.N.; Alyahya, S.A.; Al-Anbr, M.N.; Gopinath, K.; Sudha, A. Nanosilver crystals capped with Bauhinia acuminata phytochemicals as new antimicrobials and mosquito larvicides. J. Trace Elem. Med. Biol. 2018, 50, 146–153. [Google Scholar] [CrossRef]
- Gopinath, K.; Kumaraguru, S.; Bhakyaraj, K.; Thirumal, S.; Arumugam, A. Eco-friendly synthesis of TiO2, Au and Pt doped TiO2 nanoparticles for dye sensitized solar cell applications and evaluation of toxicity. Superlattices Microstruct. 2016, 92, 100–110. [Google Scholar] [CrossRef]
- Gopinath, K.; Sundaravadivelan, C.; Arumugam, A. Green synthesis, characterization of silver, gold and bimetallic nanoparticles using bark extract of Terminalia arjuna and their larvicidal activity against malaria vector, Anopheles stephensi. Int. J. Recent Sci. Res. 2013, 4, 904–910. [Google Scholar]
- Mahboob, S.; Nivetha, R.; Gopinath, K.; Balalakshmi, C.; Al-Ghanim, K.A.; Al-Misned, F.; Ahmed, Z.; Govindarajan, M. Facile synthesis of gold and platinum doped titanium oxide nanoparticles for antibacterial and photocatalytic activity: A photodynamic approach. Photodiagnosis Photodyn. Ther. 2021, 33, 102148. [Google Scholar] [CrossRef]
- Choudhury, B.; Dey, M.; Choudhury, A. Defect generation, dd transition, and band gap reduction in Cu-doped TiO2 nanoparticles. Int. Nano Lett. 2013, 3, 25. [Google Scholar] [CrossRef]
- Huang, D.; Zheng, C.; Huang, L.; Wu, X.; Chen, L. Linear and nonlinear optical properties of ultrafine WO3 nanorods. Optik 2018, 156, 994–998. [Google Scholar] [CrossRef]
- Huang, L.; Xu, H.; Li, Y.; Li, H.; Cheng, X.; Xia, J.; Xu, Y.; Cai, G. Visible-light-induced WO3/gC3N4 composites with enhanced photocatalytic activity. Dalton Trans. 2013, 42, 8606–8616. [Google Scholar] [CrossRef] [PubMed]
- Mane, A.; Navale, S.; Sen, S.; Aswal, D.; Gupta, S.; Patil, V. Nitrogen dioxide (NO2) sensing performance of p-polypyrrole/n-tungsten oxide hybrid nanocomposites at room temperature. Org. Electron. 2015, 16, 195–204. [Google Scholar] [CrossRef]
- Li, S.; Lin, P.; Zhao, L.; Wang, C.; Liu, D.; Liu, F.; Sun, P.; Liang, X.; Liu, F.; Yan, X. The room temperature gas sensor based on Polyaniline@flower-like WO3 nanocomposites and flexible PET substrate for NH3 detection. Sens. Actuators B Chem. 2018, 259, 505–513. [Google Scholar] [CrossRef]
- Bai, S.; Zhang, K.; Wang, L.; Sun, J.; Luo, R.; Li, D.; Chen, A. Synthesis mechanism and gas-sensing application of nanosheet-assembled tungsten oxide microspheres. J. Mater. Chem. A 2014, 2, 7927–7934. [Google Scholar] [CrossRef]
- Liu, F.; Chen, X.; Xia, Q.; Tian, L.; Chen, X. Ultrathin tungsten oxide nanowires: Oleylamine assisted nonhydrolytic growth, oxygen vacancies and good photocatalytic properties. RSC Adv. 2015, 5, 77423–77428. [Google Scholar] [CrossRef]
- Badilescu, S.; Ashrit, P. Study of sol–gel prepared nanostructured WO3 thin films and composites for electrochromic applications. Solid State Ion. 2003, 158, 187–197. [Google Scholar] [CrossRef]
- De Wijs, G.; De Groot, R. Amorphous WO3: A first-principles approach. Electrochim. Acta 2001, 46, 1989–1993. [Google Scholar] [CrossRef]
- Xu, L.; Yin, M.-L. Agx@WO3 core-shell nanostructure for LSP enhanced chemical sensors. Sci. Rep. 2014, 4, 6745. [Google Scholar] [CrossRef]
- Boruah, P.J.; Khanikar, R.R.; Bailung, H. Synthesis and characterization of oxygen vacancy induced narrow bandgap tungsten oxide (WO3−x) nanoparticles by plasma discharge in liquid and its photocatalytic activity. Plasma Chem. Plasma Process. 2020, 40, 1019–1036. [Google Scholar] [CrossRef]
- Kavitha, N.; Venkatesh, K.; Palani, N.; Ilangovan, R. Fungus mediated biosynthesis of WO3 nanoparticles using Fusarium solani extract. Proc. AIP Conf. Proc. 2017, 1832, 050130. [Google Scholar]
- Parthibavarman, M.; Karthik, M.; Prabhakaran, S. Facile and one step synthesis of WO3 nanorods and nanosheets as an efficient photocatalyst and humidity sensing material. Vacuum 2018, 155, 224–232. [Google Scholar] [CrossRef]
- Kasi, G.; Viswanathan, K.; Sadeghi, K.; Seo, J. Optical, thermal, and structural properties of polyurethane in Mg-doped zinc oxide nanoparticles for antibacterial activity. Prog. Org. Coat. 2019, 133, 309–315. [Google Scholar] [CrossRef]
- Duan, G.; Chen, L.; Jing, Z.; De Luna, P.; Wen, L.; Zhang, L.; Zhao, L.; Xu, J.; Li, Z.; Yang, Z. Robust antibacterial activity of tungsten oxide (WO3−X) nanodots. Chem. Res. Toxicol. 2019, 32, 1357–1366. [Google Scholar] [CrossRef] [PubMed]
- Ahmed, B.; Ojha, A.K.; Singh, A.; Hirsch, F.; Fischer, I.; Patrice, D.; Materny, A. Well-controlled in-situ growth of 2D WO3 rectangular sheets on reduced graphene oxide with strong photocatalytic and antibacterial properties. J. Hazard. Mater. 2018, 347, 266–278. [Google Scholar] [CrossRef]

Disclaimer/Publisher’s Note: The statements, opinions and data contained in all publications are solely those of the individual author(s) and contributor(s) and not of MDPI and/or the editor(s). MDPI and/or the editor(s) disclaim responsibility for any injury to people or property resulting from any ideas, methods, instructions or products referred to in the content. |
© 2023 by the authors. Licensee MDPI, Basel, Switzerland. This article is an open access article distributed under the terms and conditions of the Creative Commons Attribution (CC BY) license (https://creativecommons.org/licenses/by/4.0/).
Share and Cite
Thanakkasaranee, S.; Kasi, G.; Kadhiravan, S.; Arumugam, A.; Al-Ghanim, K.A.; Riaz, M.N.; Govindarajan, M. Synthesis of Tungsten Oxide Nanoflakes and Their Antibacterial and Photocatalytic Properties. Fermentation 2023, 9, 54. https://doi.org/10.3390/fermentation9010054
Thanakkasaranee S, Kasi G, Kadhiravan S, Arumugam A, Al-Ghanim KA, Riaz MN, Govindarajan M. Synthesis of Tungsten Oxide Nanoflakes and Their Antibacterial and Photocatalytic Properties. Fermentation. 2023; 9(1):54. https://doi.org/10.3390/fermentation9010054
Chicago/Turabian StyleThanakkasaranee, Sarinthip, Gopinath Kasi, Sivasamy Kadhiravan, Ayyakannu Arumugam, Khalid A. Al-Ghanim, Mian Nadeem Riaz, and Marimuthu Govindarajan. 2023. "Synthesis of Tungsten Oxide Nanoflakes and Their Antibacterial and Photocatalytic Properties" Fermentation 9, no. 1: 54. https://doi.org/10.3390/fermentation9010054
APA StyleThanakkasaranee, S., Kasi, G., Kadhiravan, S., Arumugam, A., Al-Ghanim, K. A., Riaz, M. N., & Govindarajan, M. (2023). Synthesis of Tungsten Oxide Nanoflakes and Their Antibacterial and Photocatalytic Properties. Fermentation, 9(1), 54. https://doi.org/10.3390/fermentation9010054

